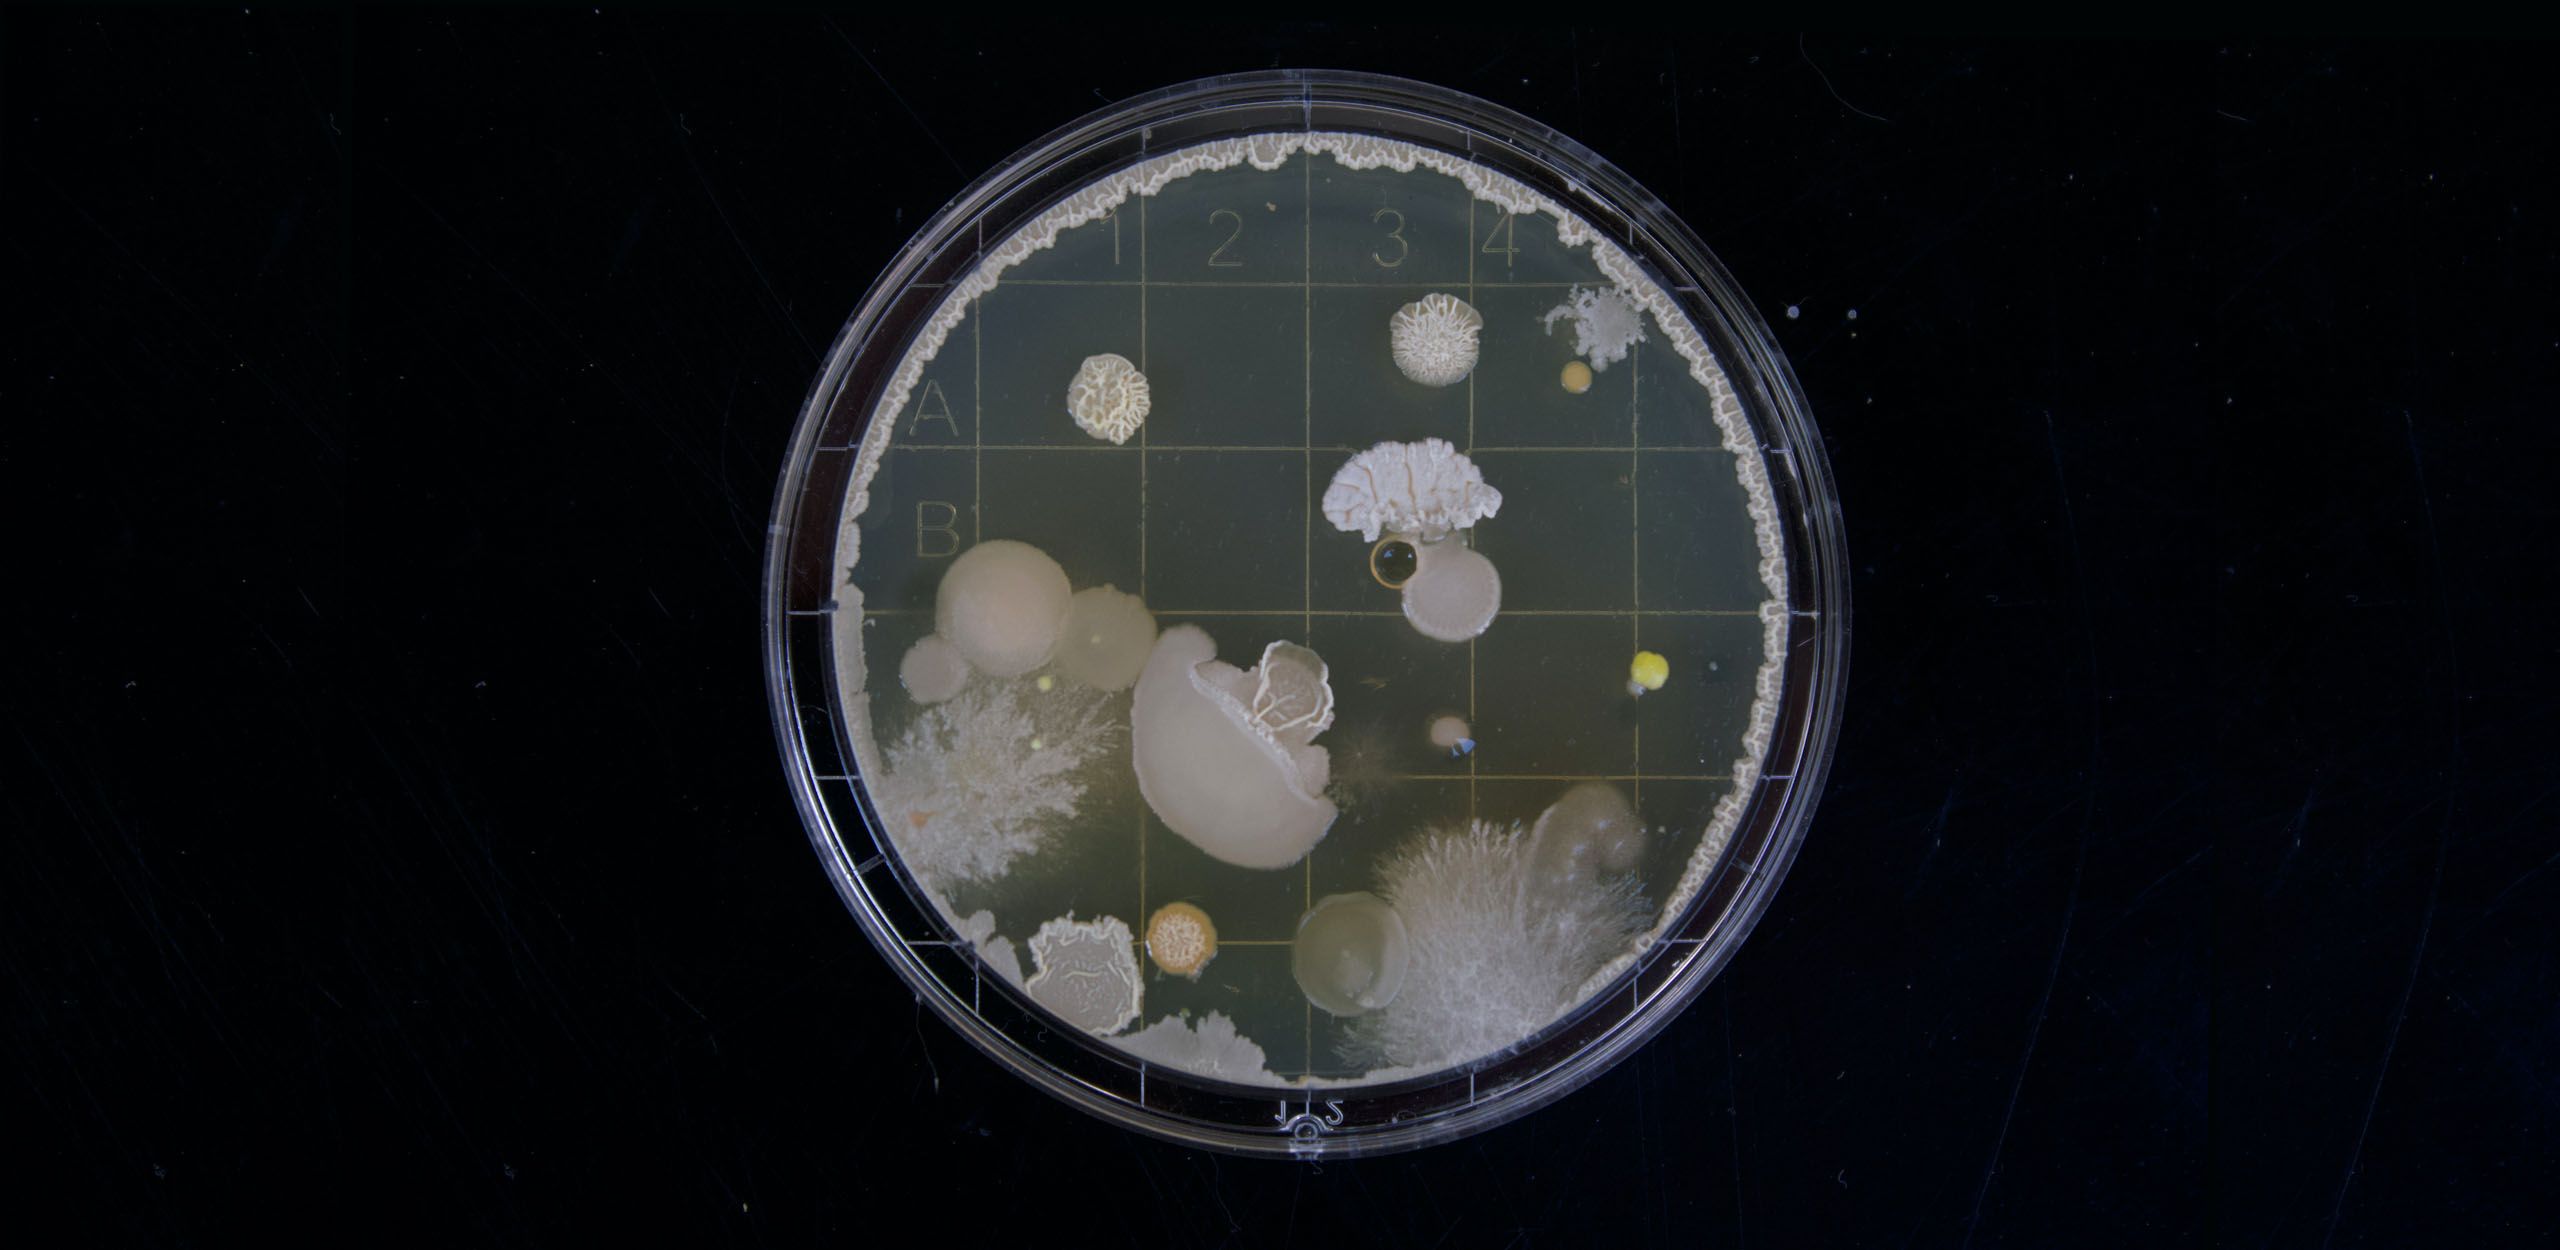
Are Essential Oils a Cure for Monster Bacteria like MRSA? - Volume 8, Number 1

Raindrop Messenger
The Raindrop Messenger is the official newsletter of CARE, The Center for Aromatherapy Research and Education.
In each issue of The Raindrop Messenger you will find articles and essays on a variety of topics related to health and longevity. Our hope is to be informative and, perhaps, inspiring to you for the benefit of your physical, mental, social, emotional, and spiritual life. The Raindrop Messenger is also a friendly way of keeping you abreast of CARE’s ongoing programs, activities and helpful books and videos.
The articles published in The Raindrop Messenger and in this archive are not copyrighted. You are encouraged to copy them, reprint them, and share them with friends. We would appreciate acknowledgment of their source by a statement to the effect:
“Reprinted from The Raindrop Messenger, a FREE e-newsletter. To subscribe, visit the web site: http://www.RaindropTraining.com.”
Raindrop Messenger
Evergreen Trees in Your Home

Relationship and Connection

Which Oil Should I Use?